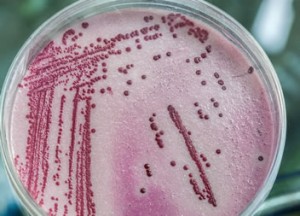

Quelle que soit votre activité, les nuisibles sont une source de coûts et de désagréments importants. Facteurs de maladies, ils déprécient votre patrimoine et vos équipements tout en exaspérant ceux qui doivent supporter leur présence. La seule façon pour en finir ? Faire appel à des professionnels. AWEN SERVICES vous apporte une solution sur mesure et adaptée à vos contraintes et vos besoins. Dans le respect de la réglementation en vigueur, de l’environnement et des règles de l’art, nous vous proposons des réponses opérationnelles et pérennes.
Les entreprises, quelle que soit leur activité, doivent garantir un environnement sain et sécurisé à leurs collaborateurs et à leurs visiteurs. Les techniques d’assainissement regroupées sous l’appellation « 3D » — Dératisation, Désinsectisation, Désinfection — jouent un rôle clé dans la prévention des risques sanitaires et la préservation de la qualité de vie au travail.
Dératisation : En finir avec les rongeurs

Une intervention de dératisation menée par des professionnels est le moyen le plus efficace et le plus rapide de vous débarrasser des rongeurs. AWEN SERVICES vous garantit une action fiable, rapide et pérenne afin d’en finir avec les invasions de rongeurs.
Souris, surmulots rats noirs, mulots, … les rongeurs sont une plaie qui peut sérieusement perturber votre environnement. Non seulement ils dégradent votre patrimoine et vos équipements, contaminant les denrées et les matériaux, mais ils véhiculent également un grand nombre de germes et de maladies.
Vous prémunir contre la présence des rongeurs est indispensable. Cela vous évite des surcoûts importants et c’est la garantie d’un environnement sain et préservé.
Pour des opérations de dératisation, ponctuelles ou en urgence, nous vous offrons le concours de personnel qualifié et habilité afin de vous proposer une réponse adaptée à vos attentes et à vos contraintes.
Désinsectisation : La désinsectisation au service de votre tranquillité

Garantissez à votre personnel un environnement sain et préservé tout en protégeant vos bâtiments, vos installations, vos productions et votre équipement. Que ce soit pour lutter contre les insectes rampants ou volants, AWEN SERVICES vous propose un service d’expert pour empêcher leur prolifération par un traitement curatif adapté et de contrôler leur population dans le cadre d’une action préventive.
Punaises, mouches et fourmis, guêpes, frelons, teignes, nous traitons les zones infestées avec des moyens adaptés et homologués pour endiguer toute prolifération et pour surveiller le développement de colonies potentielles.
En fonction du diagnostic établi et des configurations et usages de vos locaux, nous mettons en oeuvre les solutions les plus adaptées. Pulvérisation ou nébulisation, systèmes de piégeage par phéromone, destructeurs électroniques, appâts, destruction des nids, … nous maîtrisons toutes les techniques et usage des produits biocides.
N’attendez pas d’être infestés pour prendre les bonnes mesures ! Capable d’intervenir très rapidement lors d’une situation d’urgence, AWEN SERVICES s’adapte à vos horaires et à vos contraintes pour vous proposer des réponses adaptées, pour une efficacité prouvée et une satisfaction garantie !
Désinfection : La désinfection professionnelle pour la salubrité de vos sites
Un nettoyage et une désinfection efficaces permettent de garantir la conformité de vos installations en matière d’hygiène et de sécurité et la prévention des maladies infectieuses. Avec AWEN SERVICES tous les risques relatifs à l’hygiène et à la sécurité sont identifiés, évalués et maitrisés et nous adoptons des procédures de travail en conformité avec les standards reconnus.
Pour garantir la salubrité de vos sites, nous vous proposons des traitements curatifs mais aussi un entretien préventif et un contrôle régulier des réseaux d’assainissement. Canalisations, bac à graisse, colonnes de vide-ordure… AWEN SERVICES intervient sur l’ensemble de vos réseaux d’assainissement.
De plus, qu’il s’agisse de rongeurs ou d’insectes, les nuisibles peuvent transporter des maladies ou des bactéries transmissibles à l’homme. Les rats peuvent véhiculer la maladie de Weil ou l’Escherichia coli, les cafards peuvent propager la salmonellose, la dysenterie ou encore la Tuberculose. Vos installations ne peuvent pas risquer d’infecter leurs collaborateurs. C’est pourquoi AWEN SERVICES, en complément de ses services anti-nuisibles, vous propose un service de désinfection professionnelle complet et expert.
Notre service de désinfection microbienne permet de traiter les surfaces et les volumes des locaux, notamment ceux destinés à la préparation des denrées alimentaires, mais aussi tous les espaces communs en appliquant des désinfectants bactéricides, virucides et fongicides.
Notre expertise
IDENTIFICATION
Espèces cibles, biologie et comportements, notre connaissance des nuisibles nous permet d’identifier précisément les problèmes posés.
DIAGNOSTIC
Zones infectées, étendue de l’infestation, produits ou équipements à utiliser, nous définissons précisément un diagnostic de la situation et un plan d’action.
TRAITEMENT
Traitement préventif ou curatif, ponctuel ou régulier, AWEN SERVICES met en oeuvre une réponse adaptée et certifiée qui vous protège dans la durée avec un résultat garanti.



